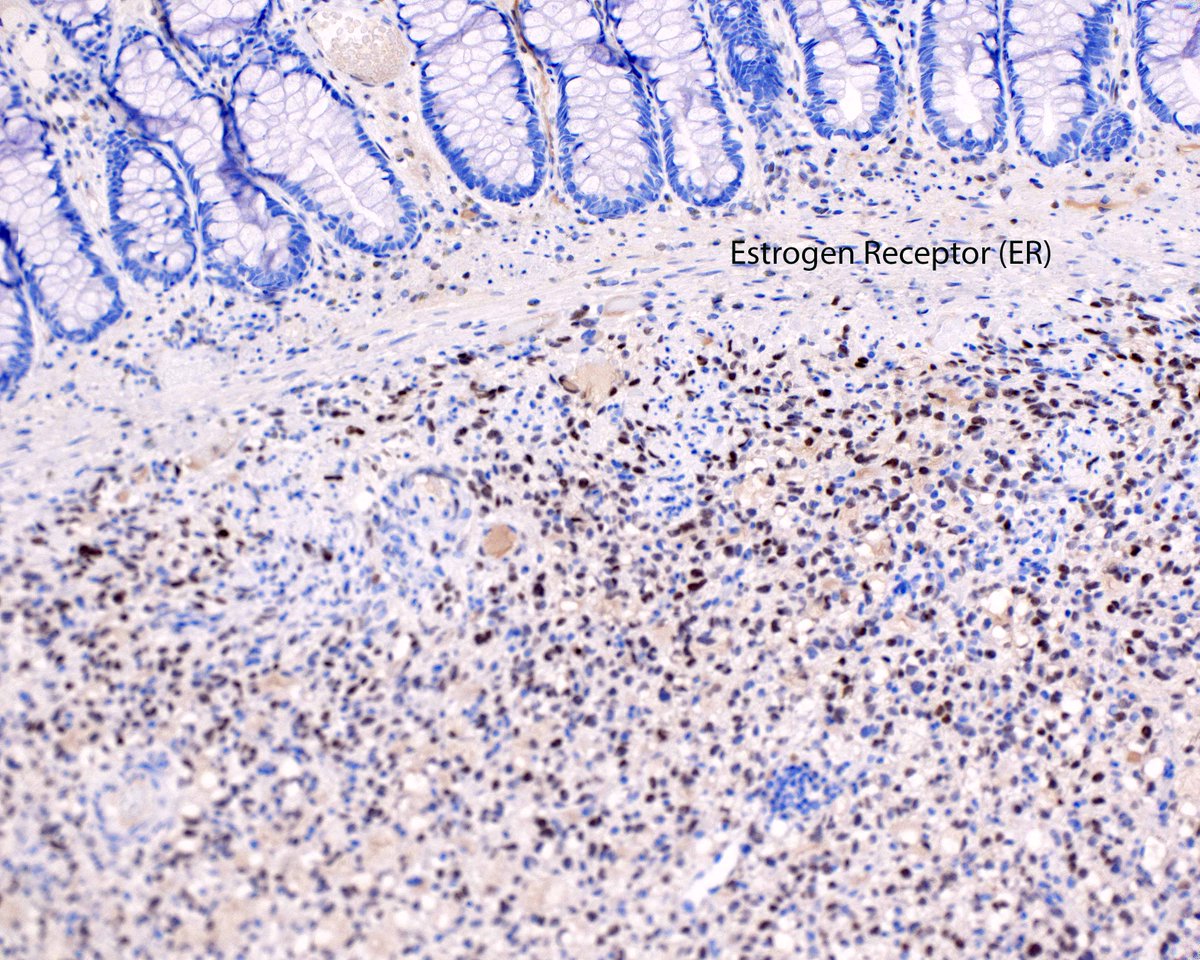
Low grade endometrial stromal sarcoma presenting as a colon polyp.  That lobulated appearance is a clue.

Mihai Danciu
@m_danciu
Professor of Pathology, Head of Pathology Department, Grigore T. Popa University of Medicine and Pharmacy Iasi, Romania
ID: 864184253055213573
http://www.clinicalcases.eu 15-05-2017 18:22:36
722 Tweet
521 Takipçi
250 Takip Edilen




#MTPathUnknown #256 Answer Explanatory slide 1/2 Mary Mathew pathology98 Yasmine Buderbala Good ID @JulianBurton15 I really enjoyed your fantastic reply! I just thought this image nicely portrayed the histologic features of the pituitary gland from low power for students



34 year old female abdomen, sent in as cyst #dermpath David Terrano Mariantonieta Tirado Allison Osmond MD MSc FRCPC Dermpath_doc_trish Henry YANG Olaleke Folaranmi Pathology Jerad Gardner, MD Christine J. Ko, MD Lorand Kis James Sampson American Society of Dermatopathology #BSTPath








Eye enucleation from an adult. Your diagnosis? Where does it usually metastasize first? Answers: kikoxp.com/posts/5912. Amazing pics by Dr. Monica Evans. #pathologists #pathology #pathTwitter #grosspath #Ophthotwitter #ophtho #MedStudentTwitter #medtwitter Dr. Glaucomflecken


Incidental 8 mm finding in a case of thyroid follicular nodular disease. IHC: TTF1 -, ERG +. No mitotic activity, no necrosis. Pepe Jiménez Heffernan A. Cristina Vargas Barry McGinn Xiaoyin "Sara" Jiang, MD (She/Her) Carlos Nieves Olaleke Folaranmi Sanjay Mukhopadhyay Bin Xu Ashok Parameswaran Olaleke Folaranmi Lorand Kis